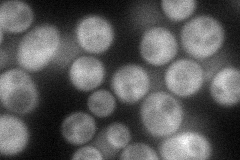
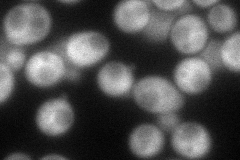
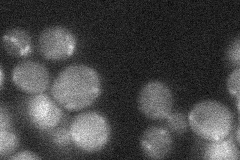
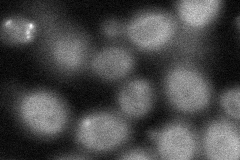
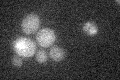

View description
Cytoplasmic protein of unknown function, has similarity to Vps5p; potential Cdc28p substrate; contains a Phox homology (PX) domain and specifically binds phosphatidylinositol 3-phosphate (PtdIns-3-P)
Localization:
Intensity:
Fold change:
Significance:
-
C’ GFP library in SD

cytosol22.47 -
N' NOP1pr-GFP in SD
cytosol62.3527 -
N' TEF2pr-mCherry in SD
cytosol86.0306 -
N' NATIVEpr-GFP in SD
cytosol22.9461 -
N' TEF2pr-VC and Cyto-VN in SD
cytosol49.2364 -
C’ GFP library in SD+DTT

cytosol22.791.01No -
C’ GFP library in SD+H2O2

cytosol22.891.01No -
C’ GFP library in Starvation Media
cytosol17.260.76No -
C’ GFP library on the background of Pup2-DaMP

cytosol -
C’ GFP library on the background of CCT mutant

cytosol23.10861.02798No
